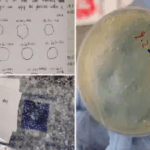

Good news for yellow metal buyers as Gold price drops, with 24-carat gold witnessing a decline on Tuesday, June 10. Moreover, the popular choice for jewellers, 22-carat gold, prized for its durability, was priced at Rs 89,540 for 10 grams.
The price of 24-carat gold dropped on Tuesday, with 10 grams of it selling at Rs 97,680, according to Good Returns. However, Silver prices witnessed a surge and are now standing at Rs 1,08,100 per kilogram, according to Good Returns.
In Mumbai, the price of ten grams of 24-carat gold is equivalent to the prices in Kolkata, Chennai and Hyderabad at Rs 97,680. The rate of 10 grams of 24-carat gold today in Delhi is Rs 97,830.
The price of ten grams of 22-carat gold in Mumbai is Rs 89,540, the same as in Kolkata, Bengaluru, Chennai and Hyderabad. The price of ten grams of 22-carat gold in Delhi is Rs 89,690.
In Delhi, Mumbai, and Kolkata, one kilogram of silver is selling at Rs 1,08,100. In Chennai and Hyderabad, 1 kilogram of silver is selling at Rs 1,17,900.
Gold Price In Major Cities
| City | Gold Price (22-Carat/10 gm) | Gold Price (24-Carat/10 gm) | Silver Price (Rs/kg) |
| Delhi | Rs 89,690 | Rs 97,830 | Rs 1,08,100 |
| Noida | Rs 89,690 | Rs 97,830 | Rs 1,08,100 |
| Lucknow | Rs 89,690 | Rs 97,830 | Rs 1,08,100 |
| Mumbai | Rs 89,540 | Rs 97,680 | Rs 1,08,100 |
| Bengaluru | Rs 89,540 | Rs 97,680 | Rs 1,08,100 |
| Chennai | Rs 89,540 | Rs 97,680 | Rs 1,17,900 |
| Pune | Rs 89,540 | Rs 97,680 | Rs 1,08,100 |
| Ahmedabad | Rs 89,590 | Rs 97,730 | Rs 1,08,100 |
| Kolkata | Rs 89,540 | Rs 97,680 | Rs 1,08,100 |
| Hyderabad | Rs 89,540 | Rs 97,680 | Rs 1,17,900 |
Source: Good Returns
How Gold Prices In India Are Determined?
Contrary to popular belief, gold prices in India aren’t solely driven by physical gold demand and supply. Instead, they’re significantly influenced by trading activities on major global markets, including the London OTC spot market and the COMEX gold futures market.
Furthermore, other factors like global events, political issues, central bank decisions, and currency changes can also fuel the change in the prices of the precious metal.
How To Check The Purity Of Gold
Here are a few tips to check the purity of the gold:
1. Look for a hallmark: The best way is to look for the hallmark. 22-carat gold, also known as 916 gold, will have a hallmark stamp on its back of 916.
2. Check for the BIS Standard Mark: On all the jewellery, you can look for a triangle with the letters “BIS” underneath to ensure the purity of the gold.
3. Perform an acid test: An acid test can be performed under guidance, where you can test the gold with nitric acid to check its purity.
4. Colour test: The yellow metal stays yellow always, it remains untarnished.